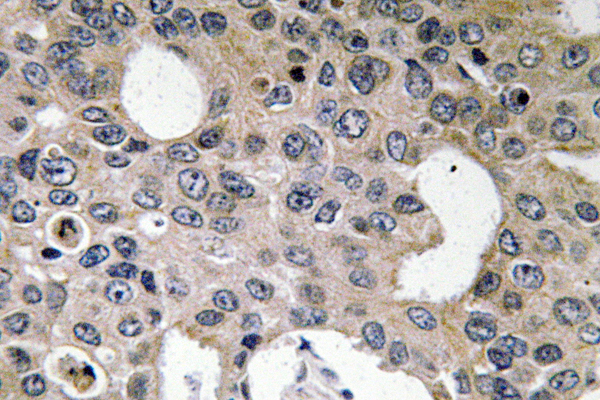
Anti-IL-4Ralpha Antibody

Primary
Product group Antibodies
ApplicationsWestern Blot, ELISA
ReactivityHuman, Mouse
- SizePrice
Product group Antibodies
ApplicationsImmunoFluorescence, ELISA
ReactivityHuman, Mouse
- SizePrice
Product group Antibodies
Anti-S6K-alpha2 AntibodyA96681
ApplicationsELISA, ImmunoHistoChemistry
ReactivityHuman, Mouse
- SizePrice
Product group Antibodies
Anti-IL-5Ralpha AntibodyA96682
ApplicationsELISA, ImmunoHistoChemistry
ReactivityHuman, Mouse
- SizePrice
Product group Antibodies
Anti-IL-4Ralpha AntibodyA96683
ApplicationsELISA, ImmunoHistoChemistry
ReactivityHuman, Mouse
- SizePrice
Product group Antibodies
Anti-CSGALNACT2 AntibodyA96684
ApplicationsELISA, ImmunoHistoChemistry
ReactivityHuman, Mouse
- SizePrice
Product group Antibodies
ApplicationsWestern Blot, ImmunoHistoChemistry
ReactivityHuman
- SizePrice
Product group Antibodies
ApplicationsWestern Blot, ImmunoHistoChemistry
ReactivityHuman
- SizePrice
Product group Antibodies
ApplicationsImmunoHistoChemistry
ReactivityHuman
- SizePrice
Product group Antibodies
Anti-Keratin 7 AntibodyA96688
ApplicationsImmunoFluorescence, Western Blot, ELISA, ImmunoHistoChemistry
ReactivityHuman
- SizePrice
Product group Antibodies
Anti-Cyclin E1 AntibodyA96689
ApplicationsImmunoFluorescence, Western Blot, ELISA, ImmunoHistoChemistry
ReactivityHuman
- SizePrice
Didn't find what you were looking for?
Search through our product groups to find the right product
Back to overview

![Anti-N Cadherin Antibody [ABT-CDH2]](https://www.antibodies.com/image/catalog/96/A96685_1.jpg)
![Anti-E Cadherin Antibody [ABT-CDHE]](https://www.antibodies.com/image/catalog/96/A96686_1.jpg)
![Anti-Calretinin Antibody [ABT-Calret 1]](https://www.antibodies.com/image/catalog/96/A96687_1.jpg)

